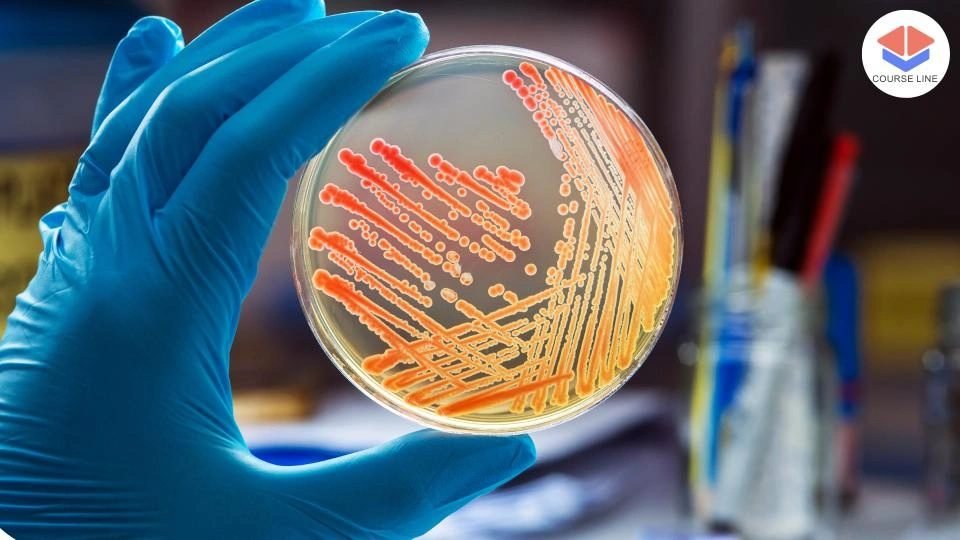

Course Features
Price
Study Method
Online | Self-paced
Course Format
Reading Material - PDF, article
Duration
4 hours, 35 minutes
Qualification
No formal qualification
Certificate
At completion
Additional info
Coming soon
- Share
Overview
Henna Artistry 101: Mastering the Basics is your complete introduction to the beautiful and intricate world of henna. This hands-on course takes you through the journey of understanding the cultural heritage, mastering the techniques, and applying henna with creativity and confidence. Whether you’re pursuing henna as a hobby or aiming to become a professional artist, this course lays the perfect foundation.
Beginning with an overview of the history and global cultural significance of henna — particularly its growing popularity in the UK — you'll learn about the tools and materials required for your henna journey. You’ll discover how to prepare your own natural henna paste, explore the safe and hygienic application process, and become skilled in creating basic lines, shapes, and traditional patterns.
From developing your first floral and geometric designs to experimenting with symbolic and thematic artwork, the course helps you build strong technical and artistic skills. It also includes expert guidance on how to apply henna to various parts of the body, ensure proper aftercare, and troubleshoot any common issues with stain quality or skin reactions.
For those interested in turning their passion into a profession, the course covers essential topics such as starting a henna art business in the UK, branding and marketing strategies, and navigating legal considerations. You'll also learn how to showcase your portfolio, collaborate effectively with clients, and establish your reputation in a competitive market.
By the end of this course, you’ll have both the artistic capability and the entrepreneurial insight to create, apply, and sell henna art confidently.
No prior experience is needed. A passion for art and creativity, along with access to basic henna supplies, is all that’s required to get started.
Who is this course for?
Henna Artistry 101: Mastering the Basics is your complete introduction to the beautiful and intricate world of henna. This hands-on course takes you through the journey of understanding the cultural heritage, mastering the techniques, and applying henna with creativity and confidence. Whether you’re pursuing henna as a hobby or aiming to become a professional artist, this course lays the perfect foundation.
Beginning with an overview of the history and global cultural significance of henna — particularly its growing popularity in the UK — you'll learn about the tools and materials required for your henna journey. You’ll discover how to prepare your own natural henna paste, explore the safe and hygienic application process, and become skilled in creating basic lines, shapes, and traditional patterns.
From developing your first floral and geometric designs to experimenting with symbolic and thematic artwork, the course helps you build strong technical and artistic skills. It also includes expert guidance on how to apply henna to various parts of the body, ensure proper aftercare, and troubleshoot any common issues with stain quality or skin reactions.
For those interested in turning their passion into a profession, the course covers essential topics such as starting a henna art business in the UK, branding and marketing strategies, and navigating legal considerations. You'll also learn how to showcase your portfolio, collaborate effectively with clients, and establish your reputation in a competitive market.
By the end of this course, you’ll have both the artistic capability and the entrepreneurial insight to create, apply, and sell henna art confidently.
No prior experience is needed. A passion for art and creativity, along with access to basic henna supplies, is all that’s required to get started.
Requirements
Henna Artistry 101: Mastering the Basics is your complete introduction to the beautiful and intricate world of henna. This hands-on course takes you through the journey of understanding the cultural heritage, mastering the techniques, and applying henna with creativity and confidence. Whether you’re pursuing henna as a hobby or aiming to become a professional artist, this course lays the perfect foundation.
Beginning with an overview of the history and global cultural significance of henna — particularly its growing popularity in the UK — you'll learn about the tools and materials required for your henna journey. You’ll discover how to prepare your own natural henna paste, explore the safe and hygienic application process, and become skilled in creating basic lines, shapes, and traditional patterns.
From developing your first floral and geometric designs to experimenting with symbolic and thematic artwork, the course helps you build strong technical and artistic skills. It also includes expert guidance on how to apply henna to various parts of the body, ensure proper aftercare, and troubleshoot any common issues with stain quality or skin reactions.
For those interested in turning their passion into a profession, the course covers essential topics such as starting a henna art business in the UK, branding and marketing strategies, and navigating legal considerations. You'll also learn how to showcase your portfolio, collaborate effectively with clients, and establish your reputation in a competitive market.
By the end of this course, you’ll have both the artistic capability and the entrepreneurial insight to create, apply, and sell henna art confidently.
No prior experience is needed. A passion for art and creativity, along with access to basic henna supplies, is all that’s required to get started.
Career path
Henna Artistry 101: Mastering the Basics is your complete introduction to the beautiful and intricate world of henna. This hands-on course takes you through the journey of understanding the cultural heritage, mastering the techniques, and applying henna with creativity and confidence. Whether you’re pursuing henna as a hobby or aiming to become a professional artist, this course lays the perfect foundation.
Beginning with an overview of the history and global cultural significance of henna — particularly its growing popularity in the UK — you'll learn about the tools and materials required for your henna journey. You’ll discover how to prepare your own natural henna paste, explore the safe and hygienic application process, and become skilled in creating basic lines, shapes, and traditional patterns.
From developing your first floral and geometric designs to experimenting with symbolic and thematic artwork, the course helps you build strong technical and artistic skills. It also includes expert guidance on how to apply henna to various parts of the body, ensure proper aftercare, and troubleshoot any common issues with stain quality or skin reactions.
For those interested in turning their passion into a profession, the course covers essential topics such as starting a henna art business in the UK, branding and marketing strategies, and navigating legal considerations. You'll also learn how to showcase your portfolio, collaborate effectively with clients, and establish your reputation in a competitive market.
By the end of this course, you’ll have both the artistic capability and the entrepreneurial insight to create, apply, and sell henna art confidently.
No prior experience is needed. A passion for art and creativity, along with access to basic henna supplies, is all that’s required to get started.
-
- History and Origins of Henna 00:10:00
- Cultural Significance in the UK and Beyond 00:10:00
- Tools and Supplies 00:10:00
-
- Preparing Henna Paste 00:10:00
- Basic Techniques for Applying Henna 00:10:00
- Safety and Hygiene 00:10:00
- Understanding Different Henna Styles 00:10:00
- Creating Basic Patterns 00:10:00
- Practicing Lines and Shapes 00:10:00
- Floral and Geometric Patterns 00:10:00
- Incorporating Symbols and Themes 00:10:00
- Designing for Special Occasions 00:10:00
- Creating a Portfolio 00:10:00
- Collaborating with Clients 00:10:00
- Building Your Reputation 00:10:00
- Premium Certificate 00:15:00
No Reviews found for this course.
Is this certificate recognized?
Yes, our premium certificate and transcript are widely recognized and accepted by embassies worldwide, particularly by the UK embassy. This adds credibility to your qualification and enhances its value for professional and academic purposes.
I am a beginner. Is this course suitable for me?
Yes, this course is designed for learners of all levels, including beginners. The content is structured to provide step-by-step guidance, ensuring that even those with no prior experience can follow along and gain valuable knowledge.
I am a professional. Is this course suitable for me?
Yes, professionals will also benefit from this course. It covers advanced concepts, practical applications, and industry insights that can help enhance existing skills and knowledge. Whether you are looking to refine your expertise or expand your qualifications, this course provides valuable learning.
Does this course have an expiry date?
No, you have lifetime access to the course. Once enrolled, you can revisit the materials at any time as long as the course remains available. Additionally, we regularly update our content to ensure it stays relevant and up to date.
How do I claim my free certificate?
I trust you’re in good health. Your free certificate can be located in the Achievement section. The option to purchase a CPD certificate is available but entirely optional, and you may choose to skip it. Please be aware that it’s crucial to click the “Complete” button to ensure the certificate is generated, as this process is entirely automated.
Does this course have assessments and assignments?
Yes, the course includes both assessments and assignments. Your final marks will be determined by a combination of 20% from assignments and 80% from assessments. These evaluations are designed to test your understanding and ensure you have grasped the key concepts effectively.
Is this course accredited?
We are a recognized course provider with CPD, UKRLP, and AOHT membership. The logos of these accreditation bodies will be featured on your premium certificate and transcript, ensuring credibility and professional recognition.
Will I receive a certificate upon completion?
Yes, you will receive a free digital certificate automatically once you complete the course. If you would like a premium CPD-accredited certificate, either in digital or physical format, you can upgrade for a small fee.
Course Features
Price
Study Method
Online | Self-paced
Course Format
Reading Material - PDF, article
Duration
4 hours, 35 minutes
Qualification
No formal qualification
Certificate
At completion
Additional info
Coming soon
- Share
Change Management
Course Line244₽52,684.51Original price was: ₽52,684.51.₽1,611.72Current price is: ₽1,611.72.Legionella Management Level 3 Advanced Diploma
Course Line245₽52,684.51Original price was: ₽52,684.51.₽1,611.72Current price is: ₽1,611.72.Free + Shipping Sales Funnel Mastery: Build High-Converting Funnels with ClickFunnels
Kazi Shofi Uddin Bablu237₽52,684.51Original price was: ₽52,684.51.₽1,611.72Current price is: ₽1,611.72.